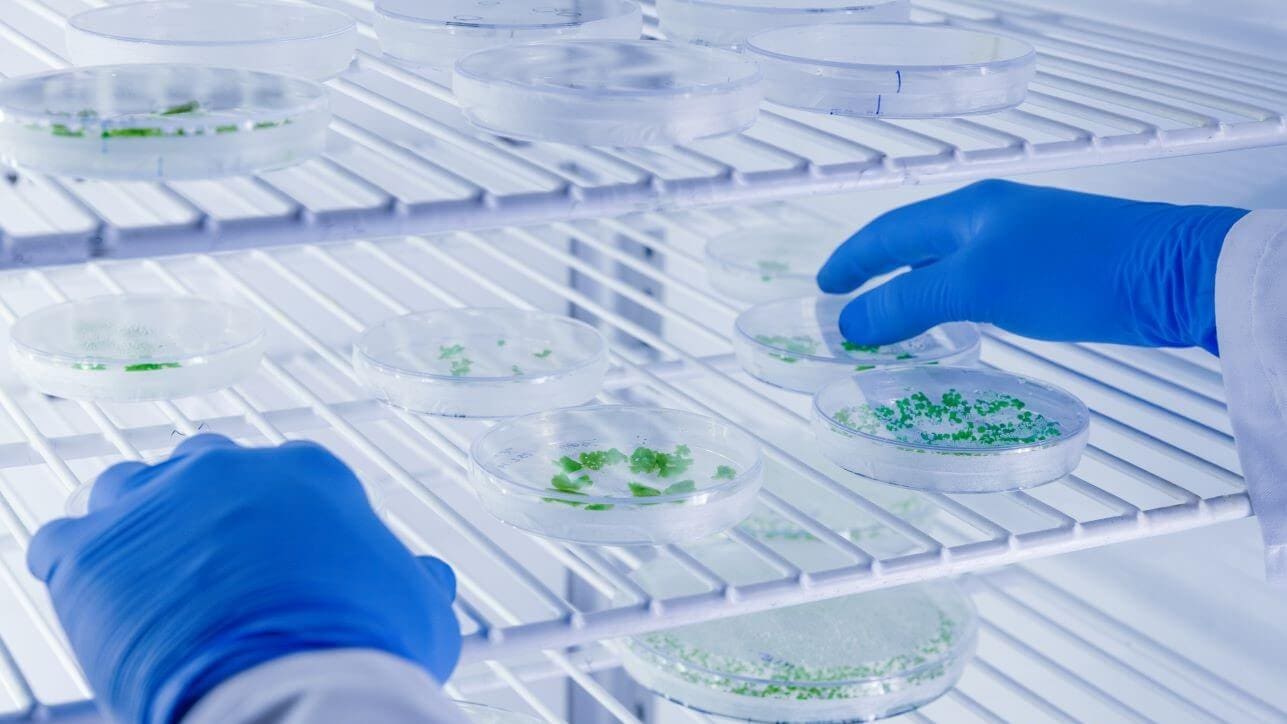

Genome editing involves the insertion, deletion, or modification of genomic DNA to improve a gene or obtain a desirable trait 1. CRISPR-Cas9 (clustered regularly interspaced short palindromic repeats and CRISPR-associated protein 9), also known as CRISPR, is a commonly used gene editing technique.
The CRISPR-Cas9 system utilises a guide RNA (gRNA) which directs the Cas9 endonuclease to the target DNA sequence, where Cas9 makes double-strand DNA breaks, inducing a DNA repair process during which precise genetic modifications are made 2.
CRISPR has been applied to many biological challenges, including genetic modification of crops in agriculture. In this article, we will delve into the applications, pros, and cons of CRISPR for genetic editing in agriculture and discuss how automation can help overcome some of the associated challenges.
Applications of CRISPR in agriculture
CRISPR is an advanced genetic editing tool with transformative potential in agriculture, with considerable benefits for farmers, society, and the planet. By leveraging this technology, some of the most pressing challenges in the realm of food security and environmental sustainability can be addressed.
The adaptability of crops is pivotal in the face of unpredictable climate conditions. CRISPR can be utilised in research to identify and characterise the genes responsible for stress responses and diseases 3. Then, genetic modification using CRISPR can render plants resistant to pests, disease, and other adversities. Notably, farmers can ensure the survival of their crops even when using herbicides to combat weeds, as the crops themselves can be made resistant. As global weather patterns shift, it becomes more crucial to equip crops with resilience against droughts, extreme temperatures, and high salinity soil.
CRISPR technology also enables enhanced crop quality. For example, crops can be altered to produce fewer allergens. CRISPR was used to create wheat strands that do not contain gluten, rendering it edible for those with coeliac disease 4.
Productivity and efficiency in farming also stand to gain. By editing genes related to plant growth, yields can be maximised. CRISPR has been applied to improve rice yield by making multiple mutations in a family of genes involved in plant growth and stress responses, with promising results 5. Crops that demand less water, fewer pesticides, and minimal fertilisers make farming more sustainable and benefit the environment. Furthermore, by extending the shelf life of produce, we can take steps towards curbing food waste. A trial showed success using CRISPR to delay mushroom browning, extending its shelf life 6.
Pros and cons of CRISPR in agriculture
Benefits of CRISPR in agriculture
There are several benefits to utilising CRISPR in genome editing within the realm of agriculture, including:
- Improved farming productivity, which has economic benefits for farmers and society
- Improved food security. Ensuring crops are resistant to adverse conditions and are not struck down by disease represents a significant step towards food security
- Improved population health. CRISPR-based genome editing is an effective way to improve the nutritional value of crops and render crops safe for people with sensitivities or allergies. It can also be used to combat deficiencies, which is particularly important in vulnerable populations
- More sustainable practices. CRISPR can make farming practices more environmentally friendly, which is crucial amid the increasingly urgent climate crisis
- CRISPR is an easy-to-use, versatile, and affordable gene editing technique
Challenges and disadvantages of CRISPR in agriculture
Despite the significant advantages of using CRISPR to genetically modify crops, there are also considerable challenges. These include:
- Precise delivery. Delivering CRISPR/Cas9 components to the correct cellular location remains a significant challenge, particularly in vivo in rigid plant cells 7. This may require novel delivery strategies or adaptation of existing ones 8
- Off-target effects. There is significant concern about gene editing techniques, including CRISPR, having off-target effects on non-target genes. Although the fidelity of CRISPR is relatively high, more work is required to improve this
- Efficiency. CRISPR is not efficient in all species of plants or at targeting some traits that are controlled by several different genes. Some crops or gene targets show lower transformation and editing efficiencies and do not obtain the desired genetic changes
- Loss of genetic diversity. Many people are concerned that genome editing using CRISPR and other techniques will lead to the narrowing of the genetic pool, making crops more susceptible to pests and disease in the long term and harming biodiversity
- Legal and regulatory challenges. Being a relatively new and rapidly advancing area of research, genetic modification of crops using CRISPR is subject to legal and regulatory challenges stemming from the lag in the time taken for laws and regulations to be updated in line with technological advances 9. Moreover, to gain approval, robust evidence must demonstrate safety and efficacy
How can automation help?
Using integrated automation systems such as Automata’s LINQ can help overcome many challenges associated with using CRISPR in agricultural research and crop production.
First, automation improves the speed and efficiency of experimental procedures and renders them highly scalable. This has the potential to accelerate research into CRISPR advancements to improve delivery precision, reduce the risk of off-target effects, and improve editing efficiency. Furthermore, automated procedures such as automated next-generation sequencing (NGS) allow researchers to sequence the genomes of crops and develop strategies to balance preventing biodiversity loss with the benefits of CRISPR gene editing.
The scalability of CRISPR workflows afforded by automation will be essential to combat the food insecurity risk posed by the growing population. Moreover, the cost benefits afforded by this enhanced scalability will be required to make CRISPR-based gene editing more accessible and widely adopted.
Finally, the enhanced precision, reduced chance of error, and improved traceability afforded by automated solutions will make it easier for reliable, robust, and reproducible safety and efficacy data to be produced and recorded, making steps towards overcoming the regulatory hurdles associated with genome editing.
To find out more about how LINQ can support CRISPR in agriculture, get in touch.
References
Gaj T, Sirk SJ, Shui S lan, Liu J. Genome-Editing Technologies: Principles and Applications. Cold Spring Harb Perspect Biol. 2016;8(12):a023754. doi:10.1101/cshperspect.a023754
2. Jinek M, Chylinski K, Fonfara I, Hauer M, Doudna JA, Charpentier E. A Programmable Dual-RNA–Guided DNA Endonuclease in Adaptive Bacterial Immunity. Science. 2012;337(6096):816-821. doi:10.1126/science.1225829
3. Zhang N, Roberts HM, Van Eck J, Martin GB. Generation and Molecular Characterization of CRISPR/Cas9-Induced Mutations in 63 Immunity-Associated Genes in Tomato Reveals Specificity and a Range of Gene Modifications. Front Plant Sci. 2020;11:10. doi:10.3389/fpls.2020.00010
4. Sánchez-León S, Gil-Humanes J, Ozuna CV, et al. Low-gluten, nontransgenic wheat engineered with CRISPR/Cas9. Plant Biotechnol J. 2018;16(4):902-910. doi:10.1111/pbi.12837
5. Miao C, Xiao L, Hua K, et al. Mutations in a subfamily of abscisic acid receptor genes promote rice growth and productivity. Proc Natl Acad Sci. 2018;115(23):6058-6063. doi:10.1073/pnas.1804774115
6. Waltz E. Gene-edited CRISPR mushroom escapes US regulation. Nature. 2016;532(7599):293-293. doi:10.1038/nature.2016.19754
7. Li L, He ZY, Wei XW, Gao GP, Wei YQ. Challenges in CRISPR/CAS9 Delivery: Potential Roles of Nonviral Vectors. Hum Gene Ther. 2015;26(7):452-462. doi:10.1089/hum.2015.069
8. Sandhya D, Jogam P, Allini VR, Abbagani S, Alok A. The present and potential future methods for delivering CRISPR/Cas9 components in plants. J Genet Eng Biotechnol. 2020;18(1):25. doi:10.1186/s43141-020-00036-8
9. Cong Gan W, P.K. Ling A. CRISPR/Cas9 in plant biotechnology: applications and challenges. BioTechnologia. 2022;103(1):81-93. doi:10.5114/bta.2022.113919

Genomics is transforming the future of agriculture. Learn how open, integrated automation…
Read more Agrigenomics: the role of automation
Watch Francis Crick Institute’s Jérôme Nicod discusses the impact of automating genomic…
Read more On-demand webinar: Thinking beyond the benchtop instruments
Sonia Jassi, Drug Discovery and Synthetic Biology Lead at Automata, examines how gene…
Read more Challenges of working with genetically edited cells